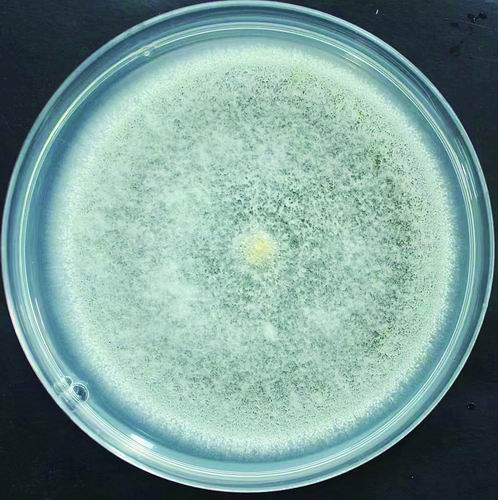

问题分诊室
绿僵菌“出马” 化汞于“无形”
发布时间: 2022-11-18
培养皿中的绿僵菌。 课题组供图
汞是三大毒性金属元素之一,是环境毒素与健康杀手。日前,浙江大学生命科学学院教授方卫国从一种常见真菌——绿僵菌身上挖掘到两个基因。它们联手,能将土壤和水体中剧毒的甲基汞和二价汞一步步转化为低毒易挥发的零价汞。
这一机制不但让绿僵菌具备了“解毒”本领,还能为与之共生的植物筑起一道天然防线,抵御汞的威胁。11月15日,这项发现在线发表于美国《国家科学院院刊》。该期刊将其作为学术亮点进行了报道,认为有望为汞污染治理提供更有效、更安全的生物修复方法。
神奇绿僵菌
绿僵菌的模样有点像放久的橘子表皮长出的青霉菌斑块,暗绿色的孢子藏在白白的菌丝下面。在农业生产上,它是一种广泛应用的生物杀虫剂。
绿僵菌能够有效感染田间的蝗虫、草地贪夜蛾和蚊虫等众多害虫,在宿主身上成长壮大、繁衍生息,最终让宿主又“绿”又“僵”,一命呜呼。
这么凶悍的绿僵菌,对植物来说却是温柔的守护神。绿僵菌活跃于植物根系,把土壤中的磷元素溶解出来,供给植物吸收。植物也将自己制造的葡萄糖“回赠”给绿僵菌。
同时,绿僵菌还能帮助植物抵御一些微生物病原菌的侵袭。绿僵菌与植物互利互惠的关系,已经在地球上延续了数百万年。
绿僵菌让方卫国痴迷多年。在他眼中,它的1.1万个基因是一座巨大的宝库,每个基因都值得好好钻研。“我们试图从基因的角度去理解有趣性状背后的机制。一方面是遗传进化机制,弄清楚什么基因导致了宏观性状及其在进化过程中的来源;另一方面是分子与生化机制,探究基因与环境交互的机理,以便更好利用它为人类服务。”方卫国说。
早在2019年,方卫国团队在美国《国家科学院院刊》发文,指出绿僵菌基因组中的18个基因是通过水平转移而来的。这些从细菌或节肢动物中获得的“外来基因”,有的能产生帮助突破昆虫体壁的物质,使绿僵菌获得了穿透昆虫“铜墙铁壁”的能力,成为侵染昆虫的“杀手锏”。
“解毒”又“挡枪”
在刚刚发表的研究中,方卫国展示了在绿僵菌上“淘”到的两件新“宝贝”——MMD和MIR。两个基因都与汞有关。众所周知,汞有不同类型的化合物和单质,毒性各不相同,其中最强的当数甲基汞。
方卫国介绍,基因MMD直接与甲基汞相关,它能产生脱甲基酶,将剧毒的甲基汞降解到二价汞形式;而MIR则能产生汞离子还原酶,让二价汞进一步转化为零价汞(汞单质),毒性进一步降低,且容易挥发到空气中,从而被活性炭吸附后轻松去除。
研究人员发现,地球上150多万种真菌中,同时拥有这两个基因的物种很少见。“这让我们非常好奇——有了这两个基因,绿僵菌是否真能抗汞?”
研究人员在培养皿中模拟了汞污染的重灾区——每升培养基中含有10毫克甲基汞。他们派出三类绿僵菌“敢死队”接受考验:敲除抗汞基因的绿僵菌、野生型绿僵菌、抗汞基因加强版绿僵菌。
结果显示,野生型绿僵菌能够在重灾区基本正常生长,不受妨碍;敲除抗汞基因的绿僵菌则奄奄一息,生存半径明显萎缩,最终“中毒身亡”;抗汞基因加强版绿僵菌,则表现出了比野生型更强的生命力。
“我们还做了一组回补实验,将两个抗汞基因重新补回到敲除基因的绿僵菌中,它们的抗汞性能又回来了。”方卫国说。研究证实,两个基因联手,巧妙化汞于“无形”,赋予了绿僵菌应对剧毒甲基汞的能力。
绿僵菌不但为自己“解毒”,还能为植物“挡枪”。研究团队开展了“玉米试毒”实验。玉米本身对甲基汞没有招架之力,但绿僵菌能及时将土壤中的甲基汞层层“解毒”,减少汞进入植物体内的机会。10天以后,重灾区的汞已不见踪影,玉米长势良好。
有望高效治理汞污染
因为从事绿僵菌抗汞特性研究,方卫国开始关注严重的汞污染问题。就目前来说,环境中的汞污染主要依靠物理吸附、植物吸附等方式进行治理,但效果并不理想或维护成本过高。
方卫国在绿僵菌身上看到了希望。“我们已经在实验室证明了与植物共生的绿僵菌可修复土壤中的汞污染,降低植物汞累积,促进植物健康与生长;绿僵菌还可以修复淡水和海水中的汞污染。”
方卫国指出,绿僵菌的维护成本很低,可依靠植物根系分泌的营养物质生长繁殖,具备一次释放、长期治理的特点。他认为,让绿僵菌在广袤的农田和山林中参与污染土壤治理,将是一种可行性很高的土壤汞污染微生物修复技术。
“目前,我们为该技术申请了多项国内外专利,正在开展相关田间试验。”方卫国对进一步研究充满信心。
据了解,由于绿僵菌是一种在农业生产中广泛应用的生物防治剂,其在生态环境中的安全性已经得到证实,批量生产技术也已成熟,实验室和现实应用的距离并不遥远。(记者 崔雪芹 通讯员 周炜)
相关论文信息:
#
特别声明:本文转载仅仅是出于传播信息的需要,并不意味着代表本网站观点或证实其内容的真实性;如其他媒体、网站或个人从本网站转载使用,须保留本网站注明的“来源”,并自负版权等法律责任;作者如果不希望被转载或者联系转载稿费等事宜,请与我们接洽。